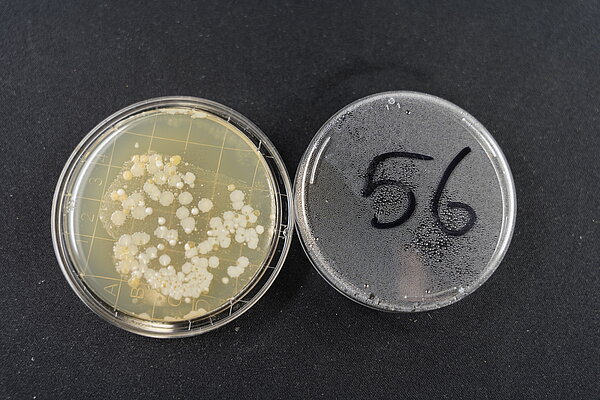
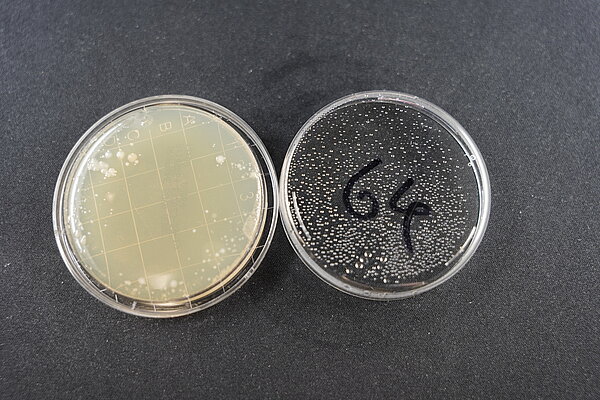

Das MicroPop Mikrobiom
Während der Vernissage von “MicroPop - Design, Wissenschaft und die Welt der Mikroben“ im SPEICHER GRAMZOW hatten Gäste die Möglichkeit Proben von Oberflächen zu nehmen, um Unsichtbares aus unserem Alltag sichtbar zu machen.
Das Mikrobiom des SPEICHERS sichtbar machen, um einen direkten Bezug zur eigenen Umwelt herzustellen, war die Idee der Tübinger Doktoranden Franziska Höhn (CMFI) und David Paccagnella. Die Gäste der Ausstellung bekamen von ihnen im eigens für die Ausstellung eingerichteten Mikrobiologischen Labor sogenannte Abklatschplatten ausgehändigt. Abklatschplatten, das sind kleine Petrischalen mit einem Nährmedium (Agar) auf dem einmal ausgebrachte Mikroorganismen hervorragende Wachstumsbedingungen finden.
Die Idee stieß auf großes Interesse und die Gäste fingen an Abdrücke im ganzen Speichergebäude zu nehmen. Die genutzten Oberflächen reichen von den Wänden und Böden des Speichers über Smartphones, Schuhe und Taschen bis hin zu Körperteilen wie Wangen, Zungen und Handflächen. Nach dem Abdruck befanden sich auf den Agarplatten Mikroorganismen die wir über fünf Tage im Brutschrank bei feucht warmen Temperaturen haben wachsen lassen. Zusammen ergeben die Abklatschplatten ein Bild des Mikrobioms des SPEICHER GRAMZOW am 06.05.2023 (die Nummern machen eine anonymisierte Wiedererkennung der eigenen Probe möglich).
Daten und Orte der Ausstellung

24. – 28. April 2023
Di – Fr | 12:00 – 19:00 Uhr
Akademie der Bildenden Künste Stuttgart
Neubau 2, Foyer
Am Weißenhof 1
D-70191 Stuttgart

06. Mai – 11. Juni 2023
Do – So | 14 – 20 Uhr
SpeicherART in DER SPEICHER GRAMZOW
Am Bahnhof 5, 17291 Gramzow/Uckermark

29. Juni – 27. August 2023
Mi – So | 10 – 17 Uhr
Do | 10 – 19 Uhr
Museum der Universität Tübingen MUT | Alte Kulturen | Schloss Hohentübingen
Burgsteige 11, 72070 Tübingen
Die Ausstellung „MicroPop – Design, Wissenschaft und die Welt der Mikroben“ zeigt Exponate, die die unsichtbare Welt der Mikroben auf künstlerische Weise spiegeln und erfahrbar machen. Sie lädt zum Nachdenken über unser Verhältnis zu den Kleinstlebewesen ein und ermöglicht es, neue Perspektiven und Ansätze zu erkunden, die sich ergeben, wenn Wissenschaft und Design zusammenkommen.
Die Idee des Projekts
Auf und in jedem menschlichen Körper leben etwa 40 bis 100 Billionen Mikroorganismen. Bis zu 1,5 kg unseres Körpergewichts können diese Mikroorganismen — Bakterien, Archaeen, Viren und Pilze — ausmachen. Zusammen bilden sie unser individuelles Mikrobiom. Die Erforschung ihrer genauen Wechselwirkungen und ihres komplexen mikrobiologischen Gleichgewichts ist heute wichtiger denn je: Ein besseres Verständnis des Mikrobioms kann uns beispielsweise helfen, bekannte und neu auftretende Infektionskrankheiten besser in den Griff zu bekommen. Das ist insbesondere auch angesichts der weltweit zunehmenden Antibiotikaresistenzen von entscheidender Bedeutung.
Die Exponate sind das Ergebnis einer im November 2021 gestarteten Kooperation zwischen dem Exzellenzcluster „Controlling Microbes to Fight Infections“ (CMFI) und dem Tübinger Forschungszentrum für Wissenschaftskommunikation der Universität Tübingen und der Staatlichen Akademie der Bildenden Künste Stuttgart (ABK) . Diese Seite gibt einen Überblick über die einzelnen Ausstellungsstücke und ihre Facetten.
Mehr zum Projekt
Leon Kokkoliadis
Presse- und Öffentlichkeitsarbeit
Tel: +49 7071 29-74707
E-Mail: leon.kokkoliadis@uni-tuebingen.de